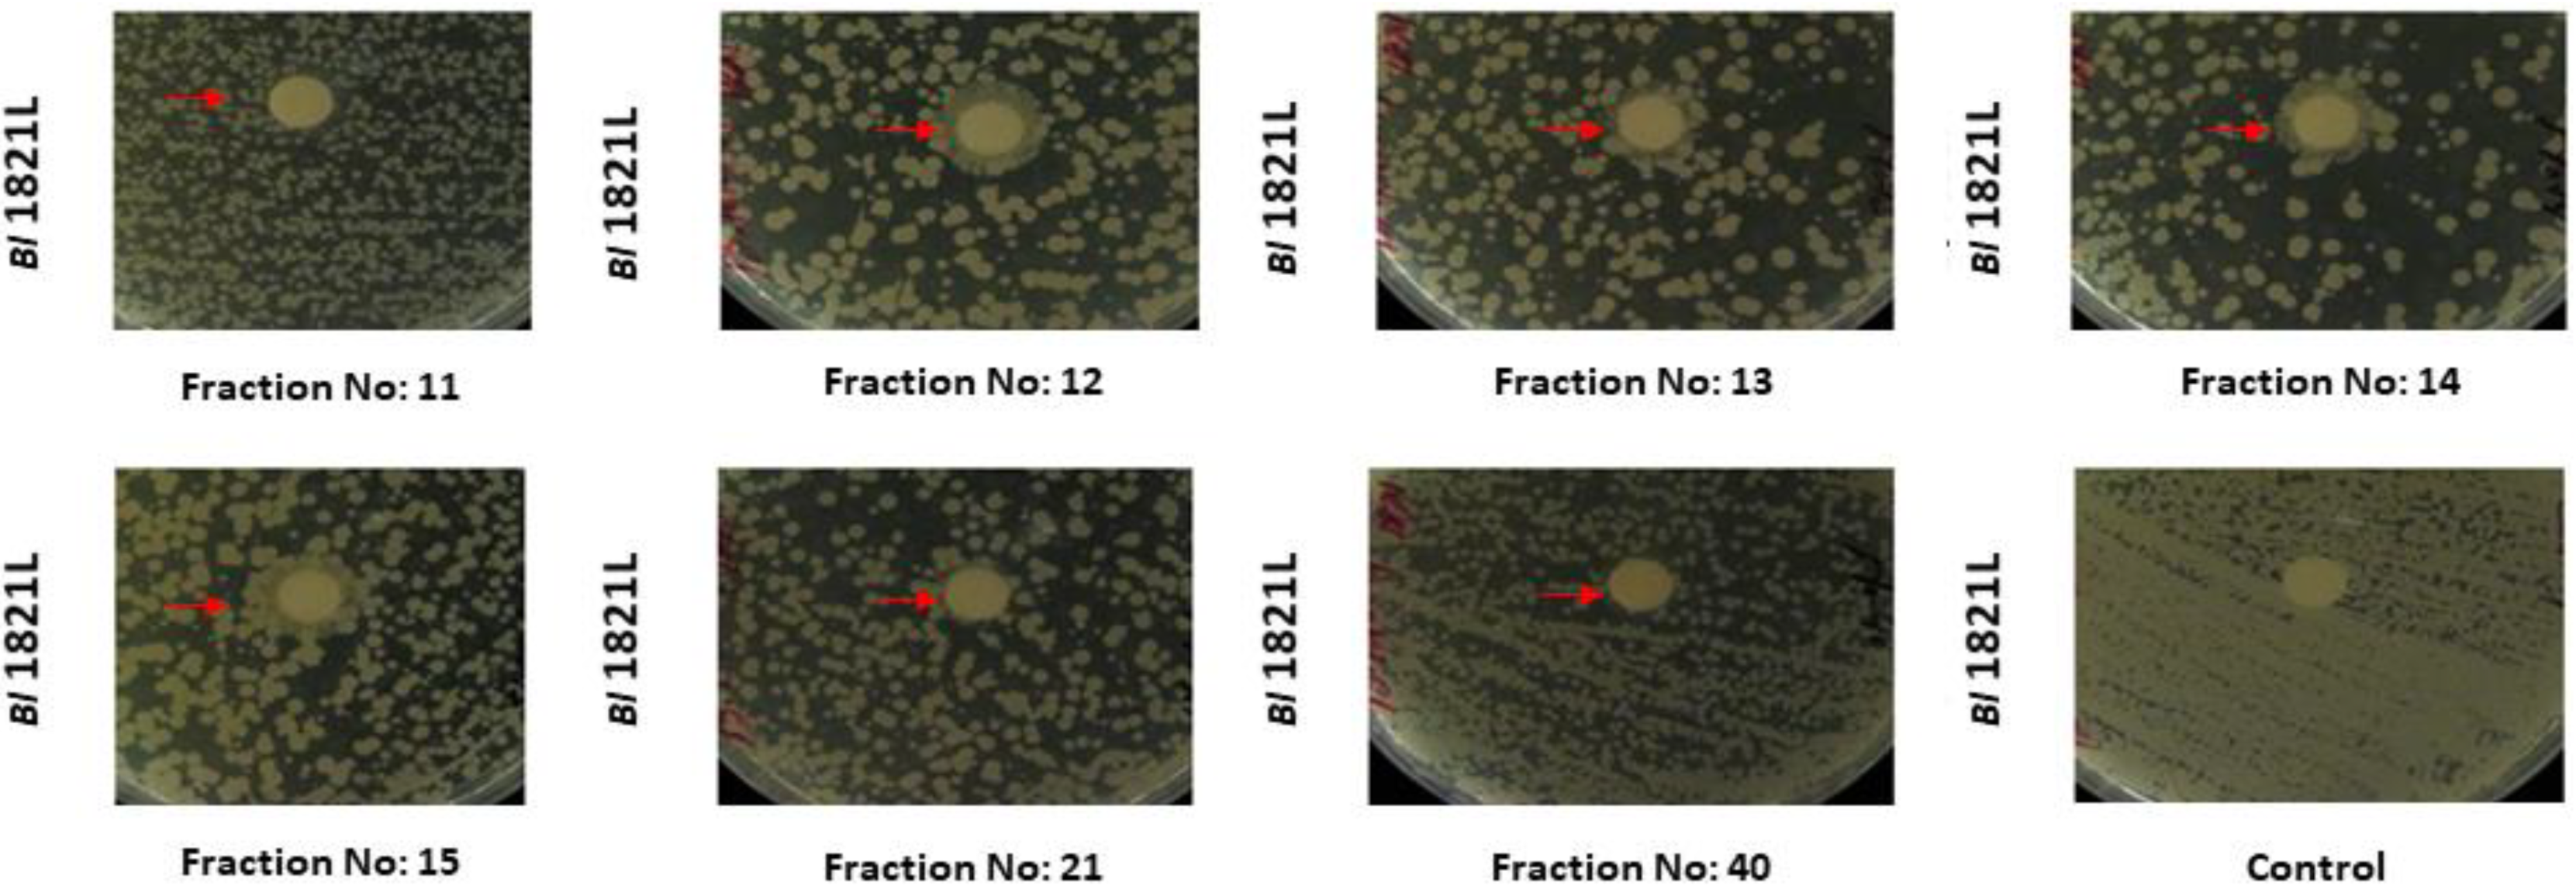
Processes 10 01932 g002 Processes 10 01932 g002
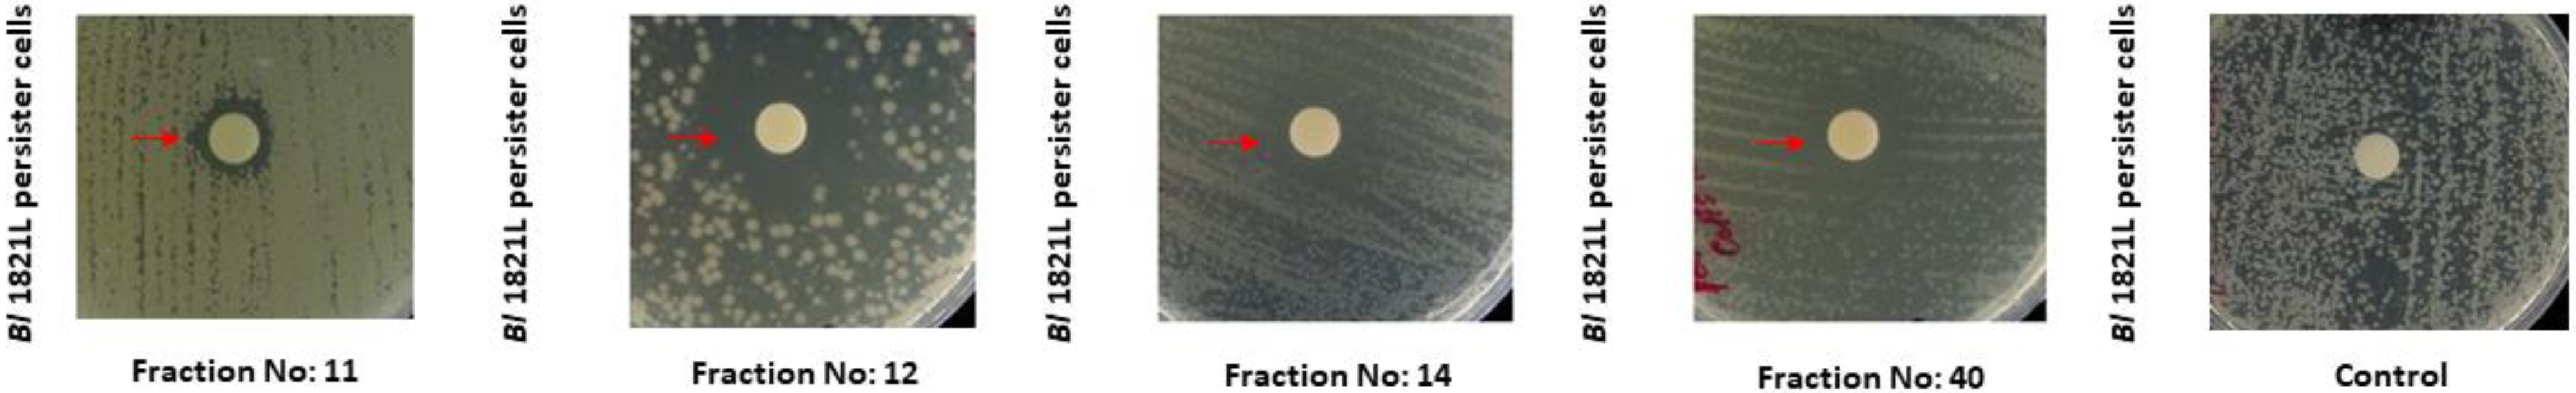
Processes 10 01932 g003 Processes 10 01932 g003

Purification of High-Molecular-Weight Antibacterial Proteins of Insect Pathogenic Brevibacillus laterosporus Isolates
Abstract
1. Introduction
2. Materials and Methods
2.1. Purification of Putative Antibacterial Proteins Using Size Exclusion Chromatography (SEC)
2.1.1. Bacterial Strains and Growth Conditions
2.1.2. Mitomycin C Induction of Putative Antibacterial Proteins
2.1.3. SEC of Putative Antibacterial Proteins
2.1.4. Assay, Protein Quantification, and SDS-PAGE Analysis of SEC Fractions
2.1.5. TEM Analysis of SEC Fractions
2.2. Purification of Putative Antibacterial Proteins Using Sucrose Density Gradient (SDG) Centrifugation
2.3. Purification of Putative Antibacterial Proteins Using Polyethylene Glycol (PEG) Precipitation
2.4. Purification of Putative Antibacterial Proteins Using Ammonium Sulphate Precipitation (ASP)
3. Results
3.1. Purification of Putative Antibacterial Proteins Using SEC
3.1.1. Purification of Bl 1821L Putative Antibacterial Protein
3.1.2. Purification of Bl 1951 Putative Antibacterial Protein

3.2. Purification of Putative Antibacterial Proteins Using SDG Centrifugation
3.2.1. Purification of Bl 1821L Putative Antibacterial Proteins
| Group A SDG (%) | Protein Concentration (µg/mL) | Zone of Inhibition Diameter (mm) | Group B SDG (%) | Protein Concentration (µg/mL) (mm) | Zone of Inhibition Diameter (mm) | ||
|---|---|---|---|---|---|---|---|
| Bl 1821L as Host Bacterium | Bl 1951 as Host Bacterium | Bl 1821L as Host Bacterium | Bl 1951 as Host Bacterium | ||||
| 10 | 75.5 | 9.0 | 12.5 | 10 | 101.0 | 12.0 | 9.5 |
| 20 | 74.9 | 9.5 | 12.0 | 20 | 117.0 | 14.0 | 10.5 |
| 30 | 89.3 | 10.5 | 12.0 | 30 | 101.0 | 12.5 | 11.0 |
| 40 | 87.2 | 9.0 | 11.5 | 40 | 100.0 | 12.0 | 11.0 |
| 50 | 116.0 | 10.0 | 10.5 | 50 | 90.1 | 11.0 | 9.5 |
| 60 | 84.1 | 9.00 | 9.0 | ||||
3.2.2. Purification of Bl 1951 Putative Antibacterial Protein
3.3. Purification of Putative Antibacterial Proteins of Bl 1821L Using Precipitation Methods
4. Discussion
5. Conclusions
Supplementary Materials
Author Contributions
Funding
Data Availability Statement
Acknowledgments
Conflicts of Interest
References
- Ghequire, M.G.; De Mot, R. The tailocin tale: Peeling off phage tails. Trends Microbiol. 2015, 23, 587–590. [Google Scholar] [CrossRef]
- Riley, M.A.; Wertz, J.E. Bacteriocin diversity: Ecological and evolutionary perspectives. Biochimie 2002, 84, 357–364. [Google Scholar] [CrossRef]
- Bradley, D.E. Ultrastructure of bacteriophage and bacteriocins. Bacteriol. Rev. 1967, 31, 230–314. [Google Scholar] [CrossRef]
- Lotz, W.; Mayer, F. Isolation and characterisation of a bacteriophage tail-like bacteriocin from a strain of Rhizobium. J. Virol. 1972, 9, 160–173. [Google Scholar] [CrossRef] [PubMed]
- Ghequire, M.G.; De Mot, R. Ribosomally encoded antibacterial proteins and peptides from Pseudomonas. FEMS Microbiol. Rev. 2014, 38, 523–568. [Google Scholar] [CrossRef]
- Rybakova, D.; Radjainia, M.; Turner, A.; Sen, A.; Mitra, A.K.; Hurst, M.R. Role of antifeeding prophage (Afp) protein Afp 16 in terminating the length of the Afp tailocin and stabilising its sheath. Mol. Microbiol. 2013, 89, 702–714. [Google Scholar] [CrossRef] [PubMed]
- Nakayama, K.; Takashima, K.; Ishihara, H.; Shinomiya, T.; Kageyama, M.; Kanaya, S.; Ohnishi, M.; Murata, T.; Mori, H.; Hayashi, T. The R-type pyocin of Pseudomonas aeruginosa is related to P2 phage, and the F-type is related to lambda phage. Mol. Microbiol. 2000, 38, 213–231. [Google Scholar] [CrossRef] [PubMed]
- Ge, P.; Scholl, D.; Prokhorov, N.S.; Avaylon, J.; Shneider, M.M.; Browning, C.; Buth, S.A.; Plattner, M.; Chakraborty, U.; Ding, K. Action of a minimal contractile bactericidal nanomachine. Nature 2020, 580, 658–662. [Google Scholar] [CrossRef]
- Saha, S.; Ojobor, C.D.; Mackinnon, E.; North, O.I.; Bondy-Denomy, J.; Lam, J.S.; Ensminger, A.W.; Maxwell, K.L.; Davidson, A.R. F-type pyocins are diverse non-contractile phage tail-like weapons for killing Pseudomonas aeruginosa. BioRxiv 2021. BioRxiv:2021.2002.2016.431561. [Google Scholar] [CrossRef]
- Michel-Briand, Y.; Baysse, C. The pyocins of Pseudomonas aeruginosa. Biochimie 2002, 84, 499–510. [Google Scholar] [CrossRef]
- Howard-Varona, C.; Hargreaves, K.R.; Abedon, S.T.; Sullivan, M.B. Lysogeny in nature: Mechanisms, impact and ecology of temperate phages. Int. Soc. Microb. Ecol. J. 2017, 11, 1511–1520. [Google Scholar] [CrossRef] [PubMed]
- Tovkach, F.I. Defective lysogeny in Erwinia carotovora. Microbiology 2002, 71, 306–313. [Google Scholar] [CrossRef]
- Fernández-Fernández, A.; Osuna, A.; Vilchez, S. Bacillus pumilus 15.1, a strain active against Ceratitis capitata, contains a novel phage and a phage-related particle with bacteriocin activity. Int. J. Mol. Sci. 2021, 22, 8164. [Google Scholar] [CrossRef]
- Scholl, D. Phage tail–like bacteriocins. Annu. Rev. Virol. 2017, 4, 453–467. [Google Scholar] [CrossRef] [PubMed]
- Boulanger, P. Purification of bacteriophages and SDS-PAGE analysis of phage structural proteins from ghost particles. In Methods in Molecular Biology; Clockie, M.R.J., Kropinski, M.A., Walker, M.J., Eds.; Molecular and Applied Aspects; Humana Press (Springer): Totowa, NJ, USA, 2009; Volume 2, pp. 227–238. [Google Scholar]
- Marichal-Gallardo, P.A.; Alvarez, M.M. State-of-the-art in downstream processing of monoclonal antibodies: Process trends in design and validation. Biotechnol. Prog. 2012, 28, 899–916. [Google Scholar] [CrossRef] [PubMed]
- Roy, I.; Mondal, K.; Gupta, M.N. Leveraging protein purification strategies in proteomics. J. Chromatogr. B 2007, 849, 32–42. [Google Scholar] [CrossRef]
- Valdés-Stauber, N.; Scherer, S. Isolation and characterisation of Linocin M18, a bacteriocin produced by Brevibacterium linens. Appl. Environ. Microbiol. 1994, 60, 3809–3814. [Google Scholar] [CrossRef]
- Shida, O.; Takagi, H.; Kadowaki, K.; Komagata, K. Proposal for two new genera, Brevibacillus gen. nov. and Aneurinibacillus gen. nov. Int. J. Syst. Evol. Microbiol. 1996, 46, 939–946. [Google Scholar] [CrossRef] [PubMed]
- Yang, X.; Yousef, A.E. Antimicrobial peptides produced by Brevibacillus spp.: Structure, classification and bioactivity: A mini review. World J. Microbiol. Biotechnol. 2018, 34, 57. [Google Scholar] [CrossRef]
- Cochrane, S.A.; Vederas, J.C. Lipopeptides from Bacillus and Paenibacillus spp.: A gold mine of antibiotic candidates. Med. Res. Rev. 2016, 36, 4–31. [Google Scholar] [CrossRef]
- Baindara, P.; Singh, N.; Ranjan, M.; Nallabelli, N.; Chaudhry, V.; Pathania, G.L.; Sharma, N.; Kumar, A.; Patil, P.B.; Korpole, S. Laterosporulin10: A novel defensin like Class IId bacteriocin from Brevibacillus sp. strain SKDU 10 with inhibitory activity against microbial pathogens. Microbiology 2016, 162, 1286–1299. [Google Scholar] [CrossRef]
- Ghadbane, M.; Harzallah, D.; Laribi, A.I.; Jaouadi, B.; Belhadj, H. Purification and biochemical characterisation of a highly thermostable bacteriocin isolated from Brevibacillus brevis strain GM100. Biosci. Biotechnol. Biochem. 2013, 77, 120681. [Google Scholar] [CrossRef] [PubMed]
- Singh, P.K.; Sharma, V.; Patil, P.B.; Korpole, S. Identification, purification and characterisation of laterosporulin, a novel bacteriocin produced by Brevibacillus sp. strain GI-9. PLoS ONE 2012, 7, e31498. [Google Scholar]
- Ruiu, L. Microbial biopesticides in agroecosystems. Agronomy 2018, 8, 235. [Google Scholar] [CrossRef]
- Baum, J.A.; CaJacob, C.A.; Feldman, P.; Heck, G.R.; Nooren, I.M.A.; Plaetinck, G.; Maddelein, W.T.; Vaughn, T.T. Methods for genetic control of insect infestations in plants and compositions thereof. U.S. Patent 10,538,783, 2020. Washington, DC: U.S. Patent and Trade Mark Office. [Google Scholar]
- Glare, T.R.; Hampton, J.G.; Cox, M.P.; Bienkowski, D.A. Novel strains of Brevibacillus laterosporus as biocontrol agents against plant pests, particularly lepidoptera and diptera. Google Patent 2014. World Intellectual Property Organisation International Bureau. [Google Scholar]
- Sampson, K.S.; Tomso, D.J.; Guo, R. Pesticidal genes from Brevibacillus and methods for their use. U.S. Patent 9,238,823, 2016. Washington, DC: U.S. Patent and Trademark Office. [Google Scholar]
- Ormskirk, M.M. Brevibacillus laterosporus as a potential biocontrol agent of the diamondback moth and other insects. Ph.D. Thesis, Lincoln University, Canterbury, New Zealand, 2017. [Google Scholar]
- Glare, T.R.; Durrant, A.; Berry, C.; Palma, L.; Ormskirk, M.M.; Cox, M.P. Phylogenetic determinants of toxin gene distribution in genomes of Brevibacillus laterosporus. Genomics 2020, 112, 1042–1053. [Google Scholar] [CrossRef] [PubMed]
- Gebhart, D.; Williams, S.R.; Bishop-Lilly, K.A.; Govoni, G.R.; Willner, K.M.; Butani, A.; Sozhamannan, S.; Martin, D.; Fortier, L.-C.; Scholl, D. Novel high-molecular-weight, R-type bacteriocins of Clostridium difficile. J. Bacteriol. 2012, 194, 6240–6247. [Google Scholar] [CrossRef] [PubMed]
- Hegarty, J.P.; Sangster, W.; Ashley, R.E.; Myers, R.; Hafenstein, S.; Stewart, D.B., Sr. Induction and Purification of Clostridium difficile phage tail-like particles. Methods Mol. Biol. 2016, 1476, 167–175. [Google Scholar] [CrossRef]
- Lee, G.; Chakraborty, U.; Gebhart, D.; Govoni, G.R.; Zhou, Z.H.; Scholl, D. F-type bacteriocins of Listeria monocytogenes: A new class of phage tail-like structures reveals broad parallel coevolution between tailed bacteriophages and high-molecular-weight bacteriocins. J. Bacteriol. 2016, 198, 2784–2793. [Google Scholar] [CrossRef] [PubMed]
- Babar, T.K.; Glare, T.R.; Hampton, J.G.; Hurst, M.R.H.; Narciso, J.O. Isolation, purification, and characterisation of a phage tail-like bacteriocin from the insect pathogenic bacterium Brevibacillus laterosporus. Biomolecules 2022, 12, 1154. [Google Scholar] [CrossRef] [PubMed]
- Babar, T.K. Heads or tails? An insight into the nature of antibacterial structures of an entomopathogenic bacterium Brevibacillus laterosporus. Ph.D. Thesis, Lincoln University, Canterbury, New Zealand, 2021. [Google Scholar]
- Rybakova, D.; Mitra, A.K.; Hurst, M.R.H. Purification and TEM of Afp and Its variants. Bio-Protocol 2014, 4, e1132. [Google Scholar] [CrossRef]
- Kirby, W.M.; Yoshihara, G.M.; Sundsted, K.S.; Warren, J.H. Clinical usefulness of a single disc method for antibiotic sensitivity testing. Antibiot. Annu. 1956, 892–897. Available online: https://pubmed.ncbi.nlmnih.gov/13425478/ (accessed on 28 August 2022).
- Bauer, A. Antibiotic susceptibility testing by a standardised single disc method. Am. J. Clin. Pathol. 1966, 45, 149–158. [Google Scholar] [CrossRef]
- Laemmli, U. SDS-PAGE Laemmli method. Nature 1970, 227, 680–685. [Google Scholar] [CrossRef]
- Blum, H.; Beier, H.; Gross, H.J. Improved silver staining of plant proteins, RNA and DNA in polyacrylamide gels. Electrophoresis 1987, 8, 93–99. [Google Scholar] [CrossRef]
- Bobay, L.-M.; Touchon, M.; Rocha, E.P.C. Pervasive domestication of defective prophages by bacteria. Proc. Natl. Acad. Sci. USA 2014, 111, 12127–12132. [Google Scholar] [CrossRef]
- Seaman, E.; Tarmy, E.; Marmur, J. Inducible phages of Bacillus subtilis. Biochemistry 1964, 3, 607–613. [Google Scholar] [CrossRef]
- Liao, W.; Song, S.; Sun, F.; Jia, Y.; Zeng, W.; Pang, Y. Isolation, characterisation and genome sequencing of phage MZTP02 from Bacillus thuringiensis MZ1. Arch. Virol. 2008, 153, 1855–1865. [Google Scholar] [CrossRef]
- Krogh, S.; Jørgensen, S.T.; Devine, K.M. Lysis genes of the Bacillus subtilis defective prophage PBSX. J. Bacteriol. 1998, 180, 2110–2117. [Google Scholar] [CrossRef]
- Patz, S.; Becker, Y.; Richert-Pöggeler, K.R.; Berger, B.; Ruppel, S.; Huson, D.H.; Becker, M. Phage tail-like particles are versatile bacterial nanomachines–A mini-review. J. Adv. Res. 2019, 19, 75–84. [Google Scholar] [CrossRef]
- Lawrence, J.E.; Steward, G.F. Purification of viruses by centrifugation. In Manual of Aquatic Viral Ecology; Wilhelm, S.W., Weinbauer, M.G., Suttle, C.A., Eds.; American Society of Limnology and Oceanography, Inc.: Rockville, MD, USA, 2010; pp. 166–181. [Google Scholar]
- Børsheim, K.Y.; Bratbak, G.; Heldal, M. Enumeration and biomass estimation of planktonic bacteria and viruses by transmission electron microscopy. Appl. Environ. Microbiol. 1990, 56, 352–356. [Google Scholar] [CrossRef]
- Kellenberger, E.; Boy de la Tour, E. On the fine structure of normal and “polymerised” tail sheath of phage T4. J. Ultrastruct. Res. 1964, 11, 545–563. [Google Scholar] [CrossRef]
- Lotz, W. Defective bacteriophages: The phage tail-like particles. In Progress in Molecular and Subcellular Biology, 1st ed.; Halin, F.E., Ed.; Springer: Berlin/Heidelberg, Germany, 1976; pp. 53–102. [Google Scholar]
- Gumpert, J.; Taubeneck, U. Microtubules in Proteus mirabilis as a result of defective lysogeny. Z. Fur Allg. Mikrobiol. 1968, 8, 101–105. [Google Scholar] [CrossRef]
- Arisaka, F.; Engel, J.; Klump, H. Contraction and dissociation of the bacteriophage T4 tail sheath induced by heat and urea. Prog. Clin. Biol. Res. 1981, 64, 365–379. [Google Scholar]
- Kurochkina, L.P.; Semenyuk, P.I.; Sykilinda, N.N.; Miroshnikov, K.A. The unique two-component tail sheath of giant Pseudomonas phage PaBG. Virology 2018, 515, 46–51. [Google Scholar] [CrossRef]
- Baechler, C.A.; Berk, R.S. Electron microscopic observations of Pseudomonas aeruginosa. Z. Fur Allg. Mikrobiol. 1974, 14, 267–281. [Google Scholar] [CrossRef]
- Bradley, D.; Dewar, C.A. The structure of phage-like objects associated with non-induced bacteriocinogenic bacteria. Microbiology 1966, 45, 399–408. [Google Scholar] [CrossRef]
- Šimoliūnas, E.; Truncaitė, L.; Rutkienė, R.; Povilonienė, S.; Goda, K.; Kaupinis, A.; Valius, M.; Meškys, R. The robust self-assembling tubular nanostructures formed by gp053 from phage vB_EcoM_FV3. Viruses 2019, 11, 50. [Google Scholar] [CrossRef]
- Nanda, A.M.; Thormann, K.; Frunzke, J. Impact of spontaneous prophage induction on the fitness of bacterial populations and host-microbe interactions. J. Bacteriol. 2015, 197, 410. [Google Scholar] [CrossRef]
- Taylor, V.L.; Fitzpatrick, A.D.; Islam, Z.; Maxwell, K.L. The diverse impacts of phage morons on bacterial fitness and virulence. Adv. Virus Res. 2019, 103, 1–31. [Google Scholar] [CrossRef]
- Lwoff, A. Lysogeny. Bacteriol Rev 1953, 17, 269–337. [Google Scholar] [CrossRef] [PubMed]
- Smarda, J.; Benada, O. Phage tail-like (high molecular-weight) bacteriocins of Budvicia aquatica and Pragia fontium (Enterobacteriaceae). Appl. Environ. Microbiol. 2005, 71, 8970–8973. [Google Scholar] [CrossRef] [PubMed]
- Germida, J.J. Spontaneous induction of bacteriophage during growth of Azospirillum brasilense in complex media. Can. J. Microbiol. 1984, 30, 805–808. [Google Scholar] [CrossRef]
- Fekete, S.; Beck, A.; Veuthey, J.L.; Guillarme, D. Theory and practice of size exclusion chromatography for the analysis of protein aggregates. J. Pharm. Biomed. Anal. 2014, 101, 161–173. [Google Scholar] [CrossRef]
- Jones, S.A.; Hurst, M.R. Purification of the Yersinia entomophaga Yen-TC toxin complex using size exclusion chromatography. Methods Mol. Biol. 2016, 1477, 39–48. [Google Scholar] [CrossRef]
- González-Pastor, J.E.; Hobbs, E.C.; Losick, R. Cannibalism by sporulating bacteria. Science 2003, 301, 510–513. [Google Scholar] [CrossRef]
- Popp, P.F.; Mascher, T. Coordinated cell death in isogenic bacterial populations: Sacrificing some for the benefit of many? J. Mol. Biol. 2019, 431, 4656–4669. [Google Scholar] [CrossRef]
- Fagundes, P.C.; Ceotto, H.; Potter, A.; de Paiva Brito, M.A.V.; Brede, D.; Nes, I.F.; de Freire Bastos, M.d.C. Hyicin 3682, a bioactive peptide produced by Staphylococcus hyicus 3682 with potential applications for food preservation. Res. Microbiol. 2011, 162, 1052–1059. [Google Scholar] [CrossRef]
- Eppert, I.; Valdés-Stauber, N.; Götz, H.; Busse, M.; Scherer, S. Growth reduction of Listeria spp. caused by undefined industrial red smear cheese cultures and bacteriocin-producing Brevibacterium lines as evaluated in situ on soft cheese. Appl. Environ. Microbiol. 1997, 63, 4812–4817. [Google Scholar] [CrossRef]
- Wilmaerts, D.; Windels, E.M.; Verstraeten, N.; Michiels, J. General mechanisms leading to persister formation and awakening. Trends Genet. 2019, 35, 401–411. [Google Scholar] [CrossRef]
- Lewis, K. Persister cells. Annu. Rev. Microbiol. 2010, 64, 357–372. [Google Scholar] [CrossRef] [PubMed]
- Shah, D.; Zhang, Z.; Khodursky, A.B.; Kaldalu, N.; Kurg, K.; Lewis, K. Persisters: A distinct physiological state of Escherichia coli. BMC Microbiol. 2006, 6, 53. [Google Scholar] [CrossRef] [PubMed]
- Jayaraman, R. Bacterial persistence: Some new insights into an old phenomenon. J. Biosci. 2008, 33, 795–805. [Google Scholar] [CrossRef] [PubMed]
- Hong, S.H.; Wang, X.; O’Connor, H.F.; Benedik, M.J.; Wood, T.K. Bacterial persistence increases as environmental fitness decreases. Microb. Biotechnol. 2012, 5, 509–522. [Google Scholar] [CrossRef]
- Kim, Y.; Wood, T.K. Toxins Hha and CspD and small RNA regulator Hfq are involved in persister cell formation through MqsR in Escherichia coli. Biochem. Biophys. Res. Commun. 2010, 391, 209–213. [Google Scholar] [CrossRef]
- Schuster, C.F.; Bertram, R. Toxin-antitoxin systems are ubiquitous and versatile modulators of prokaryotic cell fate. FEMS Microbiol. Lett. 2013, 340, 73–85. [Google Scholar] [CrossRef]
- Van Melderen, L.; Saavedra De Bast, M. Bacterial Toxin-antitoxin systems: More than selfish entities? PLoS Genet. 2009, 5, e1000437. [Google Scholar] [CrossRef]
- Michiels, J.E.; Van den Bergh, B.; Verstraeten, N.; Michiels, J. Molecular mechanisms and clinical implications of bacterial persistence. Drug Resist. Updates 2016, 29, 76–89. [Google Scholar] [CrossRef]
- Dörr, T.; Vulić, M.; Lewis, K. Ciprofloxacin causes persister formation by inducing the TisB toxin in Escherichia coli. PLoS Biol. 2010, 8, e1000317. [Google Scholar] [CrossRef]
- Keren, I.; Shah, D.; Spoering, A.; Kaldalu, N.; Lewis, K. Specialised persister cells and the mechanism of multidrug tolerance in Escherichia coli. J. Bacteriol. 2004, 186, 8172–8180. [Google Scholar] [CrossRef]
- Lewis, K. Multidrug tolerance of biofilms and persister cells. Curr. Top. Microbiol. Immunol. 2008, 322, 107–131. [Google Scholar] [CrossRef] [PubMed]
- Spoering, A.L.; Lewis, K. Biofilms and planktonic cells of Pseudomonas aeruginosa have similar resistance to killing by antimicrobials. J. Bacteriol. 2001, 183, 6746–6751. [Google Scholar] [CrossRef]
- Walker, J. Proteins structure, purification, characterisation, and functional analysis. In Principles & Techniques of Biochemistry & Molecular Biology, 6th ed.; Wilson, K., Walker, J., Eds.; Cambridge University Press: Cambridge, UK, 2005. [Google Scholar]



| Host Bacterium | SEC Fractions | Total Fractions |
|---|---|---|
| Bl 1821L | 2, 3, 4, 5, 6, 7, 8, 9, 10, 11, 12, 13, 14, 15, 16, 17, 18, 19, 21, 26, 27, 34, 37, 39, 40, 41, 42, 45, 49, 52, 53, 55, 58 | 33 |
| Bl 1951 | 2, 3, 4, 5, 7, 8, 10, 20, 21, 22, 23, 24, 25, 26, 27, 28, 29, 30, 31, 32, 41, 42, 47, 49, 52, 59, 61 | 27 |
| Host Bacterium | SEC Fractions | Total Fractions |
|---|---|---|
| Bl 1951 | 6, 9, 16, 21, 22, 27, 28, 31, 34, 40, 47, 50, 52, 55, 58, 61 | 16 |
| Bl 1821L | 8, 10, 11, 12, 13, 14, 15, 16, 18, 19, 40 | 11 |
| Group A SDG (%) | Protein Concentration (µg/mL) | Zone of Inhibition Diameter (mm) | Group B SDG (%) | Protein Concentration (µg/mL) (mm) | Zone of Inhibition Diameter (mm) | ||
|---|---|---|---|---|---|---|---|
| Bl 1821L as Host Bacterium | Bl 1951 as Host Bacterium | Bl 1821L as Host Bacterium | Bl 1951 as Host Bacterium | ||||
| 10 | 88.9 | 9.5 | 9.0 | 10 | 115.0 | 11.5 | 10.0 |
| 20 | 84.9 | 9.5 | 9.5 | 20 | 97.5 | 11.5 | 9.0 |
| 30 | 77.7 | 9.0 | 9.0 | 30 | 119.0 | 11.0 | 9.0 |
| 40 | 75.2 | 9.5 | 10.0 | 40 | 118.0 | 11.0 | 10.0 |
| 50 | 92.6 | 9.5 | 11.0 | 50 | 111.0 | 10.5 | 10.5 |
| 60 | 109.0 | 10.5 | 9.0 | ||||
Publisher’s Note: MDPI stays neutral with regard to jurisdictional claims in published maps and institutional affiliations. |
© 2022 by the authors. Licensee MDPI, Basel, Switzerland. This article is an open access article distributed under the terms and conditions of the Creative Commons Attribution (CC BY) license (https://creativecommons.org/licenses/by/4.0/).
Share and Cite
Babar, T.K.; Glare, T.R.; Hampton, J.G.; Hurst, M.R.H.; Narciso, J.O.; Beattie, A. Purification of High-Molecular-Weight Antibacterial Proteins of Insect Pathogenic Brevibacillus laterosporus Isolates. Processes 2022, 10, 1932. https://doi.org/10.3390/pr10101932
Babar TK, Glare TR, Hampton JG, Hurst MRH, Narciso JO, Beattie A. Purification of High-Molecular-Weight Antibacterial Proteins of Insect Pathogenic Brevibacillus laterosporus Isolates. Processes. 2022; 10(10):1932. https://doi.org/10.3390/pr10101932
Chicago/Turabian StyleBabar, Tauseef K., Travis R. Glare, John G. Hampton, Mark R. H. Hurst, Josefina O. Narciso, and Amy Beattie. 2022. "Purification of High-Molecular-Weight Antibacterial Proteins of Insect Pathogenic Brevibacillus laterosporus Isolates" Processes 10, no. 10: 1932. https://doi.org/10.3390/pr10101932
APA StyleBabar, T. K., Glare, T. R., Hampton, J. G., Hurst, M. R. H., Narciso, J. O., & Beattie, A. (2022). Purification of High-Molecular-Weight Antibacterial Proteins of Insect Pathogenic Brevibacillus laterosporus Isolates. Processes, 10(10), 1932. https://doi.org/10.3390/pr10101932

